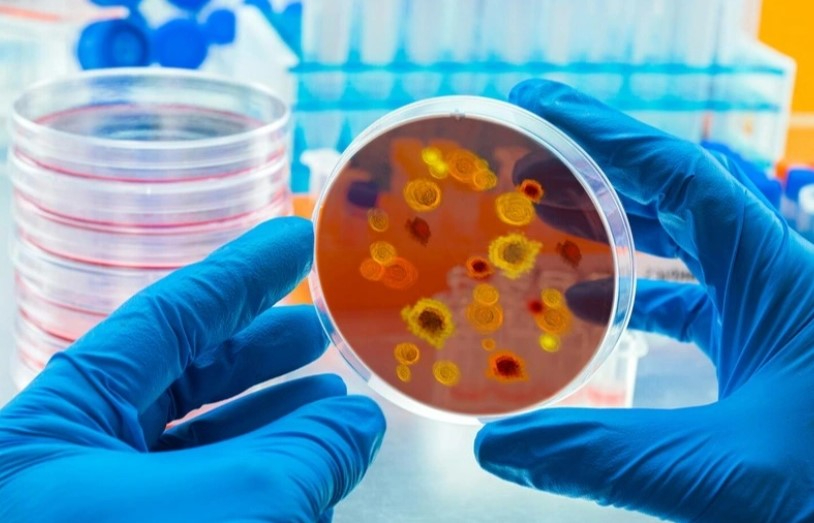

тері ауруының бұл түрі қызыл, қышитын бөртпелерді тудырады.
Фото: Report
ERNUR.KZ. Еуропа елдерінде өте қауіпті Trichophyton indotineae инфекциясы таралып жатыр, деп жазады inform.kz.
Манчестер университетінің жұқпалы аурулар жөніндегі сарапшысы Дэвид Деннингтің айтуынша, тері ауруының бұл түрі қызыл, қышитын бөртпелерді тудырады. Ол ең алдымен шап, жамбас және бөкседе пайда болады.
Ұлыбританияда соңғы үш жылда Trichophyton indotineae инфекциясының саны 500% өскен. Ауру әртүрлі жолдар арқылы жұғады.
Сарапшы Дэвид Деннинг тері ауруының таралуы тез жүретінін және бүкіл әлемде басты мәселеге айналатынын айтты.